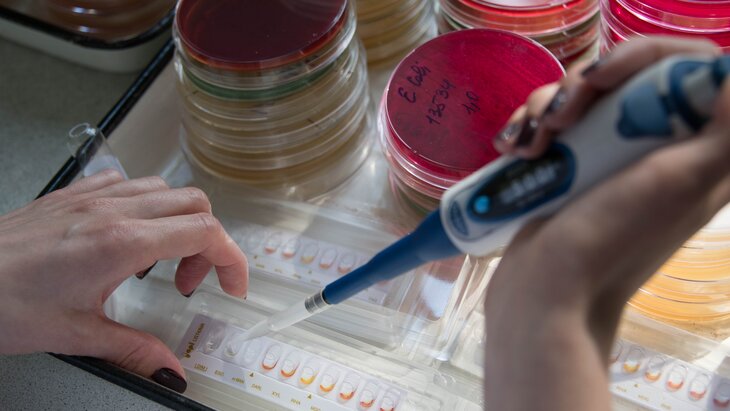

09 апреля 2020, 11:08
ОбществоНазваны регионы с самой высокой смертностью от инфекций и паразитов
Фото: портал мэра и правительства Москвы/Евгений Самарин
Жители Кемеровской области чаще всего умирают от инфекций и паразитов. На 100 тысяч населения там приходится 66,8 случая смерти по этой причине, свидетельствуют данные Росстата.
Как сообщает News.ru, в списке "лидирующих" по показателю регионов оказались Иркутская область (57,2 случая на 100 тысяч человек), Пермский край (55,2), Новосибирская область (46,7), Республика Тыва (46,5) и Свердловская область (46,4).
Наименьшие показатели – в Ингушетии (1,2), Северной Осетии (2,6) и Орловской области (3,3). В Ненецком автономном округе таких случаев не зарегистрировано совсем.
Высокая смертность от инфекций и паразитов в ряде регионов обусловлена прежним распространением героиновой наркомании и ВИЧ, считает зампред комитета Госдумы по охране здоровья Николай Говорин. Инфекционист-вирусолог София Русанова добавила, что для России характерны инфекции, которые связаны с сезонностью. При этом тяжелее всего болеют люди с хроническими патологиями, уточнила она.
По статистике, летальных исходов в результате инфекционных и паразитарных болезней в РФ стало меньше. Если в феврале 2020-го это происходило в 21,3 случая на 100 тысяч населения, в аналогичный период прошлого года – в 23,8 случая.
В прошлом году специалисты Росстата выяснили, в каких регионах России проживает наибольшее и наименьшее число граждан с хроническими заболеваниями. Чаще всего на их наличие жалуются жители Кировской области (37,3%). За ней идут Орловская, Белгородская, Архангельская и Псковская области.
Последняя оказалась "лидером" по смертности от болезней системы кровообращения в 2018 году. На 100 тысяч населения в этом регионе произошло более тысячи летальных случаев.
Высокая смертность фиксировалась в Орловской, Новгородской и Владимирской областях. Самые низкие показатели оказались в Ингушетии, Дагестане, Чечне и Туве. В Москве от болезней системы кровообращения на 100 тысяч населения в среднем скончалось 522 человека, в Санкт-Петербурге – 636 пациентов.








 Сергей Собянин поздравил артиста Юрия Башмета с днем рождения
Сергей Собянин поздравил артиста Юрия Башмета с днем рождения



























